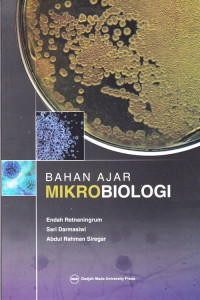

Buku P Agroteknologi
Bahan Ajar Mikrobiologi
Buku ini disusun untuk membantu para mahasiswa S-1 di Fakultas Biologi UGM dalam memahami konsep dasar teoritis mengenai mikrobiologi dasar yang hingga saat ini buku ajar dan pustaka mengenai mikrobiologi dalam bahasa Indonesia masih sangat terbatas. Selain itu buku ini diharapkan membantu mahasiswa memahami dan mempersiapkan diri dalam perkuliahan maupun melalui pustaka yang terkait (learning to know).
Ketersediaan
#
Perpustakaan Pusat
616.01 RET b
B624P
Tersedia
Informasi Detail
- Judul Seri
-
-
- No. Panggil
-
616.01 RET b
- Penerbit
- Yogyakarta : UGM Press., 2017
- Deskripsi Fisik
-
xvi,152hlm.;23cm.
- Bahasa
-
Indonesia
- ISBN/ISSN
-
978-602-386-175-0
- Klasifikasi
-
616.01 RET b
- Tipe Isi
-
-
- Tipe Media
-
-
- Tipe Pembawa
-
-
- Edisi
-
Kedua, Oktober 2018
- Subjek
-
-
- Info Detail Spesifik
-
-
- Pernyataan Tanggungjawab
-
-
Versi lain/terkait
Tidak tersedia versi lain
Lampiran Berkas
Tidak Ada Data
Komentar
Anda harus masuk sebelum memberikan komentar
Karya Umum
Karya Umum  Filsafat
Filsafat  Agama
Agama  Ilmu-ilmu Sosial
Ilmu-ilmu Sosial  Bahasa
Bahasa  Ilmu-ilmu Murni
Ilmu-ilmu Murni  Ilmu-ilmu Terapan
Ilmu-ilmu Terapan  Kesenian, Hiburan, dan Olahraga
Kesenian, Hiburan, dan Olahraga  Kesusastraan
Kesusastraan  Geografi dan Sejarah
Geografi dan Sejarah